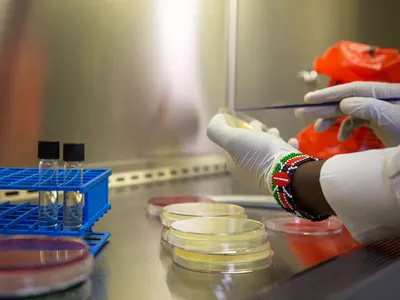

Agenția Federală de Biologie Medicală din Rusia susține că a dezvoltat șapte prototipuri de vaccin împotriva noului coronavirus, a anunțat șefa agenției, Veronika Skvortsova.

 Abonamente
Abonamente

 Ultima oră
Ultima oră
